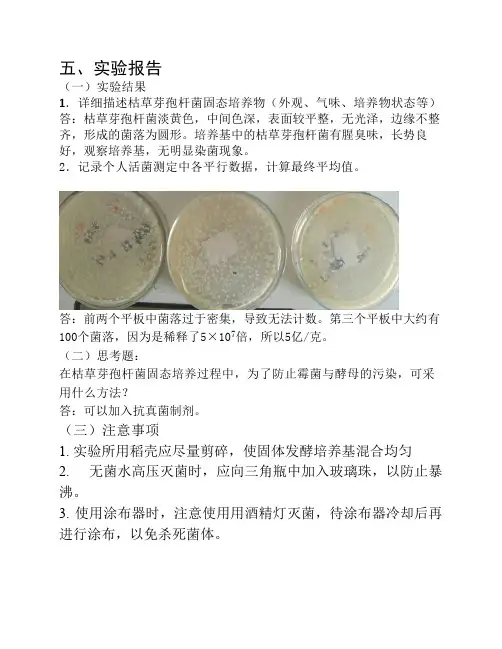

枯草芽孢杆菌-MBS发酵工艺设计
- 格式:docx
- 大小:136.82 KB
- 文档页数:10

饲用枯草芽孢杆菌发酵工艺的优化及菌剂制备吴东;刘惠琴;徐力;田永强【摘要】[目的]为饲用枯草芽孢杆菌的大规模生产奠定基础.[方法]通过单因素试验和正交试验,对发酵培养基配方及其发酵条件进行优化.[结果]饲用枯草芽孢杆菌的最佳培养基为:葡萄糖3%、酵母浸膏1.5%、磷酸氢二钠0.2%、磷酸二氢钠0.1%、硫酸镁0.1%、酵母浸粉0.5%.饲用枯草芽孢杆菌的的最适发酵条件为:温度38℃,初始pH7.0 ~7.2,摇床转速180 r/min,接种量7%.选择木屑质量与发酵液体积(m/V)的混合比为3∶5,继续高温发酵16 h,芽饱产量可达到5.18×1010CFU/g.[结论]该研究可为饲用枯草芽孢杆菌的工业化生产提供了数据支持.【期刊名称】《安徽农业科学》【年(卷),期】2015(000)019【总页数】4页(P134-137)【关键词】枯草芽孢杆菌;发酵工艺;优化;菌剂;制备【作者】吴东;刘惠琴;徐力;田永强【作者单位】兰州交通大学化学与生物工程学院,甘肃兰州730070;兰州交通大学化学与生物工程学院,甘肃兰州730070;兰州交通大学化学与生物工程学院,甘肃兰州730070;兰州交通大学化学与生物工程学院,甘肃兰州730070【正文语种】中文【中图分类】S816.6饲用抗生素的使用在我国过去的很多年内对养殖业的发展作出了突出的贡献。
但是,随着社会和科技的发展,人们对食品安全越来越重视,抗生素产生一系列负面问题(如耐药性),引起饲料用药及治疗用药量越来越高,并且过量使用抗生素容易导致动物生产能力降低[1]。
枯草芽孢杆菌是芽孢杆菌属的一种,由于其在自然界广泛分布,枯草芽孢杆菌产生孢子时能分泌许多种酶类物质和生长因子,稳定性极好,具有耐氧化、抗挤压、耐高温、耐酸等特征[2]。
此外,枯草芽孢杆菌抗逆性很强,能够储藏的时间较长,它在颗粒或粉料中都有较强的稳定性,也能够很通顺地进入动物的大小肠道生存并且能够大范围繁殖,是在微生物饲料添加剂中应用最为广泛的益生菌。


枯草芽孢杆菌液态发酵的研究李情敏;何名芳;张凤英;张超凤;陈卫平【摘要】该研究选取了一株从无花果中分离出的枯草芽孢杆菌(Bacillussubtilis)作为试验菌株,它可以产生抗逆性强的芽孢,非常适合应用于益生菌饲料加工生产.在单因素试验基础上,进行L9(33)正交试验,获得芽孢产量高、原料成本低廉的液态发酵培养基最佳配方为碎米水解液6%、酵母粉0.7%、KH2PO40.5%;对该菌的摇瓶发酵条件进行了初步研究,确定了液态发酵的最佳条件为pH值为5,温度37℃,接种量6%,转速200 r/mm,培养时间19h.在此最佳培养基配方及发酵条件下,发酵液OD600mm值可达7.38.【期刊名称】《中国酿造》【年(卷),期】2016(035)002【总页数】5页(P43-47)【关键词】枯草芽孢杆菌;液态发酵;培养基配方;培养条件;优化【作者】李情敏;何名芳;张凤英;张超凤;陈卫平【作者单位】江西农业大学食品科学与工程学院,江西南昌330045;赣州农业学校食品教研组,江西赣州341100;江西农业大学食品科学与工程学院,江西南昌330045;江西农业大学食品科学与工程学院,江西南昌330045;江西农业大学食品科学与工程学院,江西南昌330045【正文语种】中文【中图分类】TQ920.6益生菌的生理功能有很多,最重要的是可以促进肠道有益微生物的繁殖,降低病原菌数量,提高机体免疫的功能[1]。
益生菌制剂以无毒、无残留、无副作用、不污染环境等优点,使其成为了有效的抗生素替代物,在防治动植物疾病,促进机体发育,延缓人类衰老等方面被人们广泛使用[2],并成为生态循环农业中的一个重要纽带。
由于枯草芽孢杆菌(Bacillus subtilis)可形成抗逆性极强的芽孢,在稳定性方面具有先天优势,且枯草芽孢杆菌是我国农业部和美国食品药品监督管理局(Food and Drug Administration,FDA)允许作为饲料添加剂的菌种[3-4],其可以产生抑菌活性物质[5-6],也可以作为一种理想的抗生素替代物。

五、实验报告
(一)实验结果
1.详细描述枯草芽孢杆菌固态培养物(外观、气味、培养物状态等)答:枯草芽孢杆菌淡黄色,中间色深,表面较平整,无光泽,边缘不整齐,形成的菌落为圆形。
培养基中的枯草芽孢杆菌有腥臭味,长势良好,观察培养基,无明显染菌现象。
2.记录个人活菌测定中各平行数据,计算最终平均值。
答:前两个平板中菌落过于密集,导致无法计数。
第三个平板中大约有100个菌落,因为是稀释了5×107倍,所以5亿/克。
(二)思考题:
在枯草芽孢杆菌固态培养过程中,为了防止霉菌与酵母的污染,可采用什么方法?
答:可以加入抗真菌制剂。
(三)注意事项
1. 实验所用稻壳应尽量剪碎,使固体发酵培养基混合均匀
2. 无菌水高压灭菌时,应向三角瓶中加入玻璃珠,以防止暴沸。
3. 使用涂布器时,注意使用用酒精灯灭菌,待涂布器冷却后再进行涂布,以免杀死菌体。

枯草芽孢杆菌发酵培养基配方1. 引言大家好,今天咱们聊聊一个很有意思的话题,那就是枯草芽孢杆菌的发酵培养基配方。
听起来好像有点高大上,其实就是让小细菌们在一个舒适的环境里茁壮成长嘛!说到这里,你可能会问:“这枯草芽孢杆菌到底是个啥?”别急,咱慢慢来。
枯草芽孢杆菌,顾名思义,跟“枯草”有点关系,它能在各种环境下生存。
说白了,就是个“生存达人”。
咱们用它来做发酵,能够帮助咱们在农业、医药等领域有更好的应用,比如促进植物生长、提高土壤肥力等。
这可是个大忙人,嘿嘿!2. 培养基的组成2.1 基本成分那咱们要怎么调配这个培养基呢?其实挺简单的,先来看看基本成分都有哪些。
主要的配方有:1. 水:这是培养基的灵魂,少了水可不行,细菌可是“水中精灵”。
2. 营养琼脂:这个东西就像细菌的“营养快线”,能给它们提供成长所需的各种营养素。
3. 葡萄糖:别小看这糖,细菌可是特别喜欢这个,吃了能让它们“嗨”起来,分分钟活力四射。
4. 氮源:比如蛋白胨,帮助细菌合成蛋白质,细菌们得有营养才行啊。
这几个成分调配好,就像调制一杯完美的鸡尾酒,嘿嘿!2.2 其他成分除了基本成分,咱们还可以加入一些“调味剂”。
比如:1. 磷酸盐:帮助细菌更好地利用能量,别小看这个,重要得很呢。
2. 微量元素:铁、锰这些,虽然含量不多,但对细菌来说可是大补品,简直是“细菌的维生素”。
3. pH调节剂:有时候环境酸碱度不对,咱们得调调,保证细菌在最佳状态下发酵。
配方就像是做饭,想要味道好,就得多尝试,多调整,找到那个完美的平衡点!3. 制备步骤3.1 具体步骤好啦,现在咱们来聊聊怎么把这些成分变成培养基吧。
其实步骤很简单:1. 准备好所有材料:一切准备就绪,像个小厨师一样。
2. 称量成分:按比例把营养琼脂、葡萄糖、氮源等称好,别马虎,量要准。
3. 溶解:把称好的成分放进水里搅拌,直到完全溶解,就像搅拌奶茶一样,直到没有颗粒。
4. 灭菌:这一点特别重要,得把细菌们的“敌人”消灭干净,才能让咱的枯草芽孢杆菌尽情生长。

畜牧水产农家参谋-135-NONG JIA CAN MOU发酵饲料菌种配比筛选与发酵工艺优化解超平 罗春山(西昌市农业农村局,四川西昌,615000)【摘 要】试验通过选择枯草芽孢杆菌、产朊假丝酵母菌和保加利亚乳杆菌作为混合发酵剂发酵全价饲料,可以进一步提高饲料利用率。
在确定三种菌最佳混合比例的基础上,对饲料发酵参数进行进一步优化,探讨铁脚麻鸡发酵饲料的最佳工艺,为提高养殖效益提供理论依据。
【关键词】发酵饲料;菌种筛选;发酵工艺枯草芽孢杆菌是好养菌,发酵过程消耗大量的养分,维持厌氧的环境,促进厌氧菌乳酸菌生长,同时也抑制有害好养菌的生长;乳酸菌主要是产酸,对饲料质量起到关键性作用;酵母菌是兼性厌氧菌,生长环境较宽,能产酸和大量的菌体蛋白。
三种菌种的功效各不相同,采用三种菌种的最佳的混合配比,能够让其发酵的饲料营养更平衡、更利于吸收。
1 材料与方法1.1 材料酵母菌、乳酸杆菌和枯草芽孢杆菌;YPD、LB、MRS 培养基、超净工作台、摇床培养箱、发酵菌种、配合饲料等试验器材。
1.1.1 固体培养基1)YPD 固体每300mL 水中蛋白胨、酵母粉、酵母粉、琼脂糖、葡萄糖:6g、3g、6g、6g、6g 单独灭菌,然后加入300mL 无菌蒸馏水中在121℃灭菌。
2)LB 固体每300mL 水中蛋白胨、酵母粉、氯化钠:3g、1.5g、3g,在121℃灭菌锅中灭菌。
3)MRS 固体体培养基18.9g/300mL 在121℃进行灭菌。
4)生理盐水acl0.9%;Nacl:7.2g+800mL 蒸馏水。
1.1.2 液体培养基1)YPD 液体。
称酵母浸膏1g 加入80mL 蒸馏水中溶解,葡萄糖2g 加入20mL 蒸馏水中溶解,分别灭菌温度为121℃,后混合。
2)LB 液体。
酵母浸膏0.5g、蛋白胨1g、Nacl1g,加无菌蒸馏水至100mL。
3)MBS 液体。
成品:5.224g/100mL 加无菌蒸馏水,封口121℃无菌锅灭菌。

枯草芽孢杆菌的发酵学院:化工学院专业:生物工程班级:生物10-2姓名:***摘要枯草芽孢杆菌是我国农业部允许作为饲料添加剂的15种菌种之一,其已被越来越多地制成饲用微生态制剂。
因其制剂是无毒、无残留、无污染的“绿色”添加剂,故具有广阔的发展前景,并已在畜牧业、饲料业广泛应用,显示巨大的社会效益和生态效益。
通过摇床培养筛选出较适宜于枯草芽孢杆菌发酵的培养基配方,发酵培养基配方确定后,在摇床条件下,通过对温度、初始pH值、初始接种量、装液量、摇床转速等发酵条件的摸索,确定最佳发酵条件。
在摇瓶条件下优化发酵培养基和发酵工艺后,采用发酵罐进行发酵培养,对枯草芽孢杆菌在液体发酵过程中的菌体数量、pH值、总糖含量和总氮含量四个因素随时间的变化进行了观察。
枯草芽孢杆菌,是芽孢杆菌属的一种。
单个细胞0.7~0.8×2~3微米,着色均匀。
无荚膜,周生鞭毛,能运动。
革兰氏阳性菌,芽孢0.6~0.9×1.0~1.5微米,椭圆到柱状,位于菌体中央或稍偏,芽孢形成后菌体不膨大。
菌落表面粗糙不透明,污白色或微黄色。
枯草芽孢杆菌菌体生长过程中产生的枯草菌素、多粘菌素、制霉菌素、短杆菌肽等活性物质,这些物质对致病菌或内源性感染的条件致病菌有明显的抑制作用。
枯草芽孢杆菌迅速消耗环境中的游离氧,造成肠道低氧,促进有益厌氧菌生长,并产生乳酸等有机酸类,降低肠道pH值,间接抑制其它致病菌生长。
枯草芽孢杆菌菌体自身合成α-淀粉酶、蛋白酶、脂肪酶、纤维素酶等酶类,在消化道中与动物体内的消化酶类一同发挥作用,能合成维生素B1、B2、B6、烟酸等多种B族维生素,提高动物体内干扰素和巨噬细胞的活性,在饲料中应用广泛。
它还可以用来改善水质,应用在污水处理和环境保护中。
和其它微生物混合使用,还可以用于生物肥料和土地改良等关键词:枯草芽孢杆菌生长发酵活菌数第一章材料与方法1.1材料1.1.1 菌种枯草芽孢杆菌1.1.2 培养基(1)LB培养基:蛋白胨10g,酵母膏5g,NaCl10g,蒸馏水1000ml,pH为7,(可溶性淀粉20g)琼脂20g。

课程设计姓名:学院:生命科学学院系别:生物工程班级:学号:指导教师:日期: 2011年4 月 19日~5月31日前言在畜禽养殖中使用益生菌不仅可避免长期使用抗生素所引起的肠道微生态平衡被破坏、产生耐药性及药物残留等问题 ,还能提高动物的生产性能和免疫力。
枯草芽孢杆菌能改善肠道微生态环境 ,促进动物生长和提高抗病力 ,而且分泌各种消化酶类 (如蛋白酶、淀粉酶、脂肪酶和纤维素酶等 ) ,促进养分的消化、吸收 ,更重要的是枯草芽孢杆菌在不利环境条件下能形成芽孢 ,在饲料制粒、贮存及胃酸环境中仍能保持较高活性。
因此 ,枯草芽孢杆菌比其他有益微生物有着更多的优点而得到广泛的研究和应用。
试验选择在实际畜禽饲养生产中效果较好的 1株枯草芽孢杆菌 - MBS为研究对象 ,对其成长条件及培养基成分进行优化 ,为标准化生产提供依据。
利用实验获得的最优条件依次在摇瓶中及一级种子罐中扩大培养,发酵罐中扩大培养以获得所需菌体。
所得菌体经过进一步的加工处理得到菌剂等产物,以获得经济效益。
本设计为单批次液体发酵1吨枯草芽孢杆菌-MBS的发酵工艺设计,通过设计得出实际生产所需的设备及其规格要求,各理论的配比系数等参数,旨在应用到实际生产当中去。
目录设计任务书 (3)1 设计题目:单批次液体发酵1吨枯草芽孢杆菌-MBS的发酵工艺设计 (3)2 基本工艺流程: (3)3 设计依据: (3)4 设计结果: (3)设计正文 (3)1枯草芽孢杆菌简介 (3)1.1生理特性 (3)1.2作用机理 (3)1.3应用范围 (3)2设计依据 (4)2.1基本发酵工艺流程 (4)2.2总体发酵规模 (4)2.3发酵工艺设计理论参数与及工艺环节参数的选择原则 (4)3 发酵工艺流程与设备流程设计 (5)3.1工艺环节参数推算过程 (5)3.1.1接种量及装液系数 (5)3.2工艺流程简图 (5)3.3设备选型推算过程 (5)3.3.1种子罐及发酵罐 (5)3.3.2蒸汽发生器 (6)3.3.3空气压缩机 (6)3.3.4冷冻干燥机 (6)3.4实际设计的发酵工艺参数汇总表1 (6)3.5实际确定的发酵设备选型推算结果参数汇总表2 (6)3.6设备流程简图 (6)4 发酵最优条件简述 (7)5 设备汇总图表 (8)5.1 (8)5.2 (8)6 参考文献 (9)设计任务书1 设计题目:单批次液体发酵1吨枯草芽孢杆菌-MBS的发酵工艺设计2 基本工艺流程:保藏菌种(试管斜面培养)菌种摇瓶培养一级种子罐培养发酵罐发酵获得菌体3 设计依据:发酵培养类型理论接种比例(%)理想接种比例(%)理论装液系数(%)理想装液系数(%)三角瓶 1~5 1.5~2 10~20 20种子罐1~5 1.5~2 40~80 60~70 发酵罐1~5 1.5~2 56~70 60~704 设计结果:发酵级别发酵液总量(L)理论装液系数(%)理想装液系数(%)需要设备容量(L)选用设备规格及数量实际设备利用率(%)设备型号及厂家摇瓶0.4 10~20 20 0.25 4 ----------种子罐20 40~80 60~70 30 1 66.7 SY-3030 上海世远生物设备工程有限公司发酵罐1000 56~70 60~70 1500 1 66.7 TF-1500 连云港永上制药设备有限公司设计正文1枯草芽孢杆菌简介1.1生理特性枯草芽孢杆菌,是芽孢杆菌属的一种。

(10)申请公布号 (43)申请公布日 (21)申请号 201510320760.5(22)申请日 2015.06.11C12N 1/20(2006.01)C12R 1/125(2006.01)(71)申请人山东西王糖业有限公司地址256209 山东省滨州市邹平县韩店镇驻地西王工业园电厂路南侧(72)发明人王棣 王居亮 李伟 杨荣玉唐海静 夏颖颖(74)专利代理机构济南舜源专利事务所有限公司 37205代理人宋玉霞(54)发明名称一种用玉米粗蛋白粉生产枯草芽孢杆菌微生态制剂的方法(57)摘要本发明提供一种以玉米淀粉生产过程中的副产品玉米粗蛋白粉为原料生产枯草芽孢杆菌微生态制剂的生产方法,采用本方法在不添加其它碳源和氮源的条件下,单纯以玉米粗蛋白粉为营养源经过固态培养可以生产出活菌数为3000亿-5000亿/g 的枯草芽孢杆菌微生态制剂。
生产过程不需要通压缩空气,不产生任何废水废气。
减少了枯草芽孢杆菌微生态制剂的生产成本。
且所得产品以玉米纤维低聚糖为载体具有益生元的功能提高了产品质量。
(51)Int.Cl.(19)中华人民共和国国家知识产权局(12)发明专利申请权利要求书1页 说明书4页(10)申请公布号CN 104988088 A (43)申请公布日2015.10.21C N 104988088A1.一种用玉米粗蛋白粉生产枯草芽孢杆菌微生态制剂的方法,步骤如下:(1)取玉米粗蛋白粉移入固体发酵罐中,加水调到料水比为1:0.7-0.9,加氧化钙调pH 到6.0-7.0;(2)打开循环水使固体发酵罐温度上升到80-90℃后,通入蒸汽消毒30分钟;(3)待原料冷却到40℃-44℃后,加入物料干基重量1/9-1/10培养15h以后的种子液,固含量为5%;(4)维持30-40℃培养50-60h,24h后每隔6h搅拌一次物料;(5)培养到50-60h后,物料明显粘湿,有较浓的枯草芽孢杆菌特有气味,升温到44-56℃继续培养12-22h;(6)共计培养72h后移出物料,65-80℃烘干物料;(7)烘干物料水份到小于6%后,粉碎物料;(8)将粉碎的物料进行包装,取样检测产品质量。

枯草芽孢杆菌的10L发酵罐分批发酵一、实验目的:通过实验加深对发酵罐结构和分批发酵原理的认识,了解工业发酵的基本原理和方法。
二、实验原理:(一)发酵罐的结构组成原理(二)分批发酵的原理分批发酵是一种准封闭式系统,种子接种到培养基后除了气体流通外发酵液始终留在生物反应器内,在此简单系统内所有液体的流量等于零。
分批发酵过程一般可以粗分为四期:停滞期、对数生长期、稳定期和衰退期。
停滞期,即刚接种后的一段时间,细胞数目和菌量不变,因菌对新的生长环境又一适应过程,其长短主要取决于种子的活性、接种量和培养基的可利用性和浓度。
当细菌已经适应新的环境,养料充足而又无抑制生长的物质,便进入对数生长期,其比生长速率达到最大。
随着养料的减少,有害代谢产物的积累,生长不可能再无限制地继续。
此时比生长速率为养分、代谢产物和时间的函数,其细胞量仍在增加,但其比生长速率不断下降,细胞在代谢与形态方面逐渐退化,经短时间的减速后进入稳定期,此时净生长速率为零。
当养分耗竭,对生长有害代谢物在发酵液中大量积累便进入死亡期,此时生长呈负增长。
工业发酵一般不会等到菌体开始自溶时结束培养。
三、实验材料与设备(一)材料1、菌种:枯草芽孢杆菌2、培养基种子培养基:液态LB培养基发酵培养基:糖蜜10g/L,鱼粉10g/L,Nacl2.5g/L,CaCl21g/L,MgSO4·7H2O1.25g/L,KH2PO4为0.38g/L,K2HPO40.74g,麦麸为5.20 g/L,玉米粉为6.49 g/L。
(二)设备:镇江东方生工10L发酵罐四、实验步骤1.菌种的准备:取冷冻甘油种接种到平皿中,在平皿中挑取单菌落接到试管斜面。
三角瓶液体培养基摇床振荡培养。
2.发酵液的准备:先取鱼粉40g,麦麸20.8g, 玉米粉25.96g 加热至沸腾然后加入糖蜜40g 过滤培养基然后加入Nacl 10g,CaCl2 4g,MgSO4·7H2O 5g,KH2PO4为1.52g,K2HPO40.74g为2.96g。
枯草芽孢杆菌生产工艺-实验室操作1. 培养基1.1 种子培养基蛋白胨1 %,酵母浸出物0. 5 %,氯化钠1 % ,自然pH。
1.2 基础发酵培养基蔗糖1 %,蛋白胨1 %,磷酸氢二钠0. 2 %,磷酸二氢钠0. 2 %,pH 7. 0。
1.3 主要试剂蔗糖、葡萄糖、淀粉、玉米淀粉、麦芽糖、酵母浸出物、胰蛋白胨、牛肉膏、尿素、氯化铵、硫酸锰、硫酸镁、磷酸二氢钠、磷酸氢二钠、硫酸亚铁、氯化钠和氯化钙。
1.4 仪器设备控温摇床、高压蒸气灭菌锅、电子天平、pH 测定仪、无菌操作台和紫外分光光度计。
2.方法2. 1培养方法2. 1. 1菌种活化将保存的菌种转接到斜面培养基,37 ℃培养24 h,备用。
2. 1. 2种子液的制备取一环活化的菌种,接入装量为50 mL种子培养基的250mL三角瓶中,37℃,180 r/ min 培养18 h。
2. 1. 3摇瓶培养分别取1 mL 种子液,接入盛有50 mL 发酵培养基的200 mL三角瓶中(接种量为2 % ,V/ V) 。
置摇床中,30 ℃振荡培养12 h,转速为160 r/ min3. 培养条件3.1碳源以葡萄糖、蔗糖和麦芽糖为碳源时枯草芽孢杆菌的生长明显优于可溶性淀粉和玉米淀粉。
最佳碳源是葡萄糖,其次是蔗糖。
3.2氮源氮源为有机氮源时枯草芽孢杆菌的生长明显优于无机氮源。
最适氮源是酵母浸出物,从发酵成本考虑,酵母浸出物、胰蛋白胨及氯化铵组成的复合氮源较合适。
4.发酵条件4.1生长曲线接种12 h后细菌数量开始减少,枯草芽孢杆菌进入生长衰亡期。
因此,采用8~12 h 时的菌液作为菌种较合适,此时枯草芽孢杆菌为对数生长末期,既可保持高的细胞活力,又可获得尽可能多的细胞数。
4.2 初始PH在初始pH 5. 5~8范围内枯草芽孢杆菌均可良好生长,pH 为6. 0 时生长最好,说明枯草芽孢杆菌对pH 的适应性较宽,但随pH 的增大,活菌数呈下降趋势。
4.3温度枯草芽孢杆菌在25~40℃均可良好生长,其生长的最适温度为35℃。
上海交通大学学报(农业科学版)JOURNALOFSHANGHAIJIAOTONGUNIVERSITY(AGRICULTURALSCIENCE)Vol.24No.4Aug.2006第24卷第4期2006年8月摘要:采用单因素试验和正交试验对筛选出的1株生防拮抗菌———枯草芽孢杆菌(Bacillussubtilis)的液体发酵培养基和工艺条件进行优化。
确定了最佳的培养基配方为:蔗糖20g・L-1、硫酸铵5g・L-1、麸皮50g・L-1、柠檬酸三钠2.5g・L-1、K2HPO4・3H2O0.3g・L-1、MgSO4・7H2O0.5g・L-1、FeSO4・7H2O0.05g・L-1;最适发酵条件为:发酵温度30℃,初始pH值7.2,最适接种量5%;进行了100L发酵罐放大培养,20h达到生长高峰期,生长周期24h,最适放罐时间为26 ̄28h;此时所获得的菌体数量约为6×109个・mL-1。
关键词:枯草芽孢杆菌;培养基;发酵条件中图分类号:Q939文献标识码:ALiquidFermentationConditionsofBacillussubtilisHAOLin-hua1,SUNPei-xi1,JIANGZhen-bo2,CHENKao-shan2,NIUDe-qing1(1.The1stInstituteofOceanography,StateOceanicAdministration,Qingdao266061;2.EnvironmentalProtectionAdministrationofJimoCity,ShandongProvince,Qingdao266200;3.LifeScienceInstitute,ShandongUniv.,Jinan250100,China)Abstract:Bacillussubtilisispotentialtoplayanimportantbiologicalcontrolplantpathogenseffect.TheliquidfermentationmediumandtechnologicalconditionsofBacillussubtiliswereoptimizedbysinglefactorexperimentsandorthogonalexperiments.Theresultsshowedthatoptimummediumformulawassucrose20g・L-1,(NH4)2SO45g・L-1,wheatbran50g・L-1,citratesodium2.5g・L-1,KH2PO4・3H2O0.3g・L-1,MgSO4・7H2O0.5g・L-1,FeSO4・7H2O0.05g・L-1.Thefavorablefermentationconditionwasdetermined:fer-mentationtemperature30℃,initialpHvalueofmedium7.2,inoculationamount5%.Themagnifyingculturein100Lfermentationtankwasconducted,growthpeakvalueappearedin20h,growthperiod24h,andoptimumcultivatingtime26 ̄28h,andtheob-tainedbacteriumamountwasupto6×109・mL-1infermentationliquid.Keywords:Bacillussubtilis;medium;fermentationconditions20世纪60年代以来,化学农药引起的环境污染和在农产品中的残留以及病原物产生抗药性等一系列问题日益引起各国政府广泛的关注,寻找对环境友好的无公害、高效的生物农药受到普遍重视[1,2]。
课程设计姓名:学院:生命科学学院系别:生物工程班级:学号:指导教师:日期: 2011年4 月 19日~5月31日前言在畜禽养殖中使用益生菌不仅可避免长期使用抗生素所引起的肠道微生态平衡被破坏、产生耐药性及药物残留等问题 ,还能提高动物的生产性能和免疫力。
枯草芽孢杆菌能改善肠道微生态环境 ,促进动物生长和提高抗病力 ,而且分泌各种消化酶类 (如蛋白酶、淀粉酶、脂肪酶和纤维素酶等 ) ,促进养分的消化、吸收 ,更重要的是枯草芽孢杆菌在不利环境条件下能形成芽孢 ,在饲料制粒、贮存及胃酸环境中仍能保持较高活性。
因此 ,枯草芽孢杆菌比其他有益微生物有着更多的优点而得到广泛的研究和应用。
试验选择在实际畜禽饲养生产中效果较好的 1株枯草芽孢杆菌 - MBS为研究对象 ,对其成长条件及培养基成分进行优化 ,为标准化生产提供依据。
利用实验获得的最优条件依次在摇瓶中及一级种子罐中扩大培养,发酵罐中扩大培养以获得所需菌体。
所得菌体经过进一步的加工处理得到菌剂等产物,以获得经济效益。
本设计为单批次液体发酵1吨枯草芽孢杆菌-MBS的发酵工艺设计,通过设计得出实际生产所需的设备及其规格要求,各理论的配比系数等参数,旨在应用到实际生产当中去。
目录设计任务书 (3)1 设计题目:单批次液体发酵1吨枯草芽孢杆菌-MBS的发酵工艺设计 (3)2 基本工艺流程: (3)3 设计依据: (3)4 设计结果: (3)设计正文 (3)1枯草芽孢杆菌简介 (3)1.1生理特性 (3)1.2作用机理 (3)1.3应用范围 (3)2设计依据 (4)2.1基本发酵工艺流程 (4)2.2总体发酵规模 (4)2.3发酵工艺设计理论参数与及工艺环节参数的选择原则 (4)3 发酵工艺流程与设备流程设计 (5)3.1工艺环节参数推算过程 (5)3.1.1接种量及装液系数 (5)3.2工艺流程简图 (5)3.3设备选型推算过程 (5)3.3.1种子罐及发酵罐 (5)3.3.2蒸汽发生器 (6)3.3.3空气压缩机 (6)3.3.4冷冻干燥机 (6)3.4实际设计的发酵工艺参数汇总表1 (6)3.5实际确定的发酵设备选型推算结果参数汇总表2 (6)3.6设备流程简图 (6)4 发酵最优条件简述 (7)5 设备汇总图表 (8)5.1 (8)5.2 (8)6 参考文献 (9)设计任务书1 设计题目:单批次液体发酵1吨枯草芽孢杆菌-MBS的发酵工艺设计2 基本工艺流程:保藏菌种(试管斜面培养)菌种摇瓶培养一级种子罐培养发酵罐发酵获得菌体3 设计依据:发酵培养类型理论接种比例(%)理想接种比例(%)理论装液系数(%)理想装液系数(%)三角瓶 1~5 1.5~2 10~20 20种子罐1~5 1.5~2 40~80 60~70 发酵罐1~5 1.5~2 56~70 60~704 设计结果:发酵级别发酵液总量(L)理论装液系数(%)理想装液系数(%)需要设备容量(L)选用设备规格及数量实际设备利用率(%)设备型号及厂家摇瓶0.4 10~20 20 0.25 4 ----------种子罐20 40~80 60~70 30 1 66.7 SY-3030 上海世远生物设备工程有限公司发酵罐1000 56~70 60~70 1500 1 66.7 TF-1500 连云港永上制药设备有限公司设计正文1枯草芽孢杆菌简介1.1生理特性枯草芽孢杆菌,是芽孢杆菌属的一种。
单个细胞 0.7~0.8×2~3微米,着色均匀。
无荚膜,周生鞭毛,能运动。
革兰氏阳性菌,芽孢0.6~0.9×1.0~1.5微米,椭圆到柱状,位于菌体中央或稍偏,芽孢形成后菌体不膨大。
菌落表面粗糙不透明,污白色或微黄色,在液体培养基中生长时,常形成皱醭。
需氧菌。
可利用蛋白质、多种糖及淀粉,分解色氨酸形成吲哚。
在遗传学研究中应用广泛,对此菌的嘌呤核苷酸的合成途径与其调节机制研究较清楚。
广泛分布在土壤及腐败的有机物中,易在枯草浸汁中繁殖。
1.2作用机理1、枯草芽孢杆菌菌体生长过程中产生的枯草菌素、多粘菌素、制霉菌素、短杆菌肽等活性物质,这些活性物质对致病菌或内源性感染的条件致病菌有明显的抑制作用;2、枯草芽孢杆菌迅速消耗环境中的游离氧,造成肠道低氧,促进有益厌氧菌生长,并产生乳酸等有机酸类,降低肠道PH值,间接抑制其它致病菌生长;3、刺激动物免疫器官的生长发育,激活T、B淋巴细胞,提高免疫球蛋白和抗体水平,增强细胞免疫和体液免疫功能,提高群体免疫力;4、枯草芽孢杆菌菌体自身合成α-淀粉酶、蛋白酶、脂肪酶、纤维素酶等酶类,在消化道中与动物体内的消化酶类一同发挥作用;5、能合成维生素B1、B2、B6、烟酸等多种B族维生素,提高动物体内干扰素和巨噬细胞的活性。
1.3应用范围枯草芽孢杆菌不仅在饲料中应该比较广泛,在污水处理及生物肥发酵或发酵床制作中应用也相当广泛,是一种多功能的微生物.1、市政和工业污水处理,工业循环水处理,腐化槽、化粪池等处理,畜牧养殖动物废料、臭味处理,粪便处理系统,垃圾、粪坑、粪池等处理。
2、畜牧、家禽、特种动物及宠物养殖,水产养殖。
3、可以与多种菌种混配,在农业生产中具有重要作用;(如:JT菌种)MBS菌株:在畜禽养殖中使用益生菌不仅可避免长期使用抗生素所引起的肠道微生态平衡被破坏、产生耐药性及药物残留等问题 ,还能提高动物的生产性能和免疫力。
枯草芽孢杆菌能改善肠道微生态环境 ,促进动物生长和提高抗病力 ,而且分泌各种消化酶类 (如蛋白酶、淀粉酶、脂肪酶和纤维素酶等 ) ,促进养分的消化、吸收 ,更重要的是枯草芽孢杆菌在不利环境条件下能形成芽孢 ,在饲料制粒、贮存及胃酸环境中仍能保持较高活性。
因此 ,枯草芽孢杆菌比其他有益微生物有着更多的优点而得到广泛的研究和应用。
2设计依据2.1 基本发酵工艺流程a.培养菌种、用于发酵罐中的的培养基的配制;b.培养基、发酵罐以及辅助设备的消毒灭菌;c.将已培养好的纯菌株转接到发酵罐中;d.将接种到发酵罐中的菌株控制在最适条件下生长;e.回收或处理发酵过程中产生的废物和废水。
2.2总体发酵规模设计题目为单批次液体发酵1吨枯草芽孢杆菌-MBS的工艺设计,终产量为1吨的枯草芽孢杆菌-MBS菌液,设计采用1.5m3的发酵罐进行二级扩大培养;所得产品为菌体,非代谢产物;配制设备除实验室用具之外,用于生产的包括:空气压缩机,储气罐、冷冻干燥机、种子罐(30L)、发酵罐(1.5m3)、补料罐、蒸汽发生器(锅炉)、离心机、烘干机、粉碎机、混合机。
2.3发酵工艺设计理论参数与及工艺环节参数的选择原则发酵工艺设计基本参数表发酵培养类型 理论接种比例(%)理想接种比例(%)理论装液系数(%) 理想装液系数(%)三角瓶 1~5 1.5~2 10~20 20 种子罐 1~5 1.5~2 40~80 60~70 发酵罐1~51.5~256~7060~703 发酵工艺流程与设备流程设计3.1 工艺环节参数推算过程3.1.1接种量及装液系数参考《枯草芽孢杆菌-MBS 的培养条件优化研究》,确定理想接种量为1.5%-2%,最优接种量为1.5%,具体参考参数汇总图表1。
3.2工艺流程简图实验室种子培养阶段生产车间种子制备阶段3.3设备选型推算过程 3.3.1种子罐及发酵罐该发酵工艺为单批次液体发酵枯草芽孢杆菌-MBS 的发酵工艺,发酵总量为1000L ,利用种子罐扩大培养,发酵罐扩大培养:发酵罐装液量:1000L种子罐装液量:1000L*2%=20L250ml 摇瓶(4个)装液总量:20L*2%=400ml 发酵罐的理想装液系数为70%,所需发酵罐容积:发酵罐容积:1000L/70%=1428L 种子罐容积: 20L/70%=28.6L考虑市场发酵罐配型规格以及经济最优化原则,选取如下:发酵罐可选取1500L 不锈钢蒸汽灭菌发酵罐(装液系数60%—70%) 种子罐可选取30L 不锈钢蒸汽灭菌发酵罐(装液系数60%—70%)菌种 斜面培养 一级种子罐培养发酵罐培养菌种纯化 离心 烘干混合摇瓶培养参考表2则有:发酵罐实际装液系数:1000L/1500L=66.7%,在该发酵罐理想装液系数范围内。
种子罐实际装液系数:20L/30L=66.7%,在该种子罐理想装液系数范围内。
本发酵工艺为二级发酵,需要一台种子罐,一台发酵罐。
30L种子罐选取型号为SY3030的种子罐,发酵罐选取TF-1500。
(具体规格参见5.设备汇总图表)3.3.2蒸汽发生器a.根据30L种子罐的配套设备要求选取功率为12kw的杨诺型号为YN12-0.7-D蒸汽发生器;b.根据1500L发酵罐的配套设备要求选取功率为72kw的杨诺型号为YN50-0.7-D蒸汽发生器;(具体参数详见5.设备汇总图表)3.3.3空气压缩机所选取种子罐容积30L,发酵罐容积1500L,总容积为1.53m3,根据设备通气量与发酵设备总容积1:1关系,选取BLT-20A 容积流量为1.8m3的空气压缩机;(详见5.设备汇总图表)3.3.4冷冻干燥机冷冻干燥机选型时主要依据空气压缩机型号所需要的冷冻干燥机工作压力及空气处理量进行选择。
故选取型号为SCR-0023NF的风冷型空气压缩机。
(详见5.设备汇总图表)3.4实际设计的发酵工艺参数汇总表13.5实际确定的发酵设备选型推算结果参数汇总表2发酵级别发酵液总量(L)理论装液系数(%)理想装液系数(%)需要设备容量(L)选用设备规格及数量实际设备利用率(%)设备型号及厂家摇瓶0.4 10~20 20 0.25 4 ----------种子罐20 40~80 60~70 30 1 SY-3030 上海世远生物设备工程有限公司发酵罐1000 56~70 60~70 1500 1 TF-1500 连云港永上制药设备有限公司发酵级别理论接种比例(%)理想接种比例(%)发酵液总量(L)实际接种比例(%)备注发酵罐1~5 1.5~2 1000 2 种子罐1~5 1.5~2 20 2 摇瓶1~5 1.5~2 0.4 1.54 发酵最优条件简述枯草芽孢杆菌-MBS 在改良BPG 培养基中生长良好,优化后的培养基成分为葡萄糖3.8 g 、蛋白胨3.8g 、牛肉浸膏3.8g 淀粉2.3 g 、NaCl 3.3 g 、 KH 2PO 4 3.3g ;生长最佳条件是温度为 42 ℃、培养时间为 18 h 、起始 pH 值为8.0、接种量为1.5%、 转速为 240 r /min,此时OD 610值能达到1.886,菌数能达到 2.83 × 1010个 /mL 。
0023NF离心机 烘干机粉碎机混合机空气压缩机储气罐 冷冻干燥机 发酵罐补料罐 种子罐冷却水BLT -20ASY -3030(30L)TF -1500 (1500L)YN12-0.7-D蒸汽发生器 蒸汽发生器 YN72-0.7-D5.1设备名称型号规格参数空气压缩机BLT-20A容积流量[m3/min] 1.8工作压力[MPa] 1.0压缩机级数单级冷却方式风冷排气温度[℃] <环境温度+15> 电机功率[Kw] 15外型尺寸[mm] 950*650*855 机组重量[kg] 315风冷型冷冻干燥机0023NF储量[m3/min] 2.3外型尺寸[mm] 700*400*785重量[kg] 8530L种子罐SY-3030罐体全容积:30L;工作容积:12~24L罐体材质:316L不锈钢;罐盖材质:316L不锈钢罐体设计压力:0.3Mpa;夹套设计压力:0.35Mpa 配套设备:空气压缩机:静音无油,150L/min以上蒸汽发生器:全自动电加热,9KW以上1500发酵罐TF-1500装液系数65-80%罐体材质 SUS316L/SUS321。